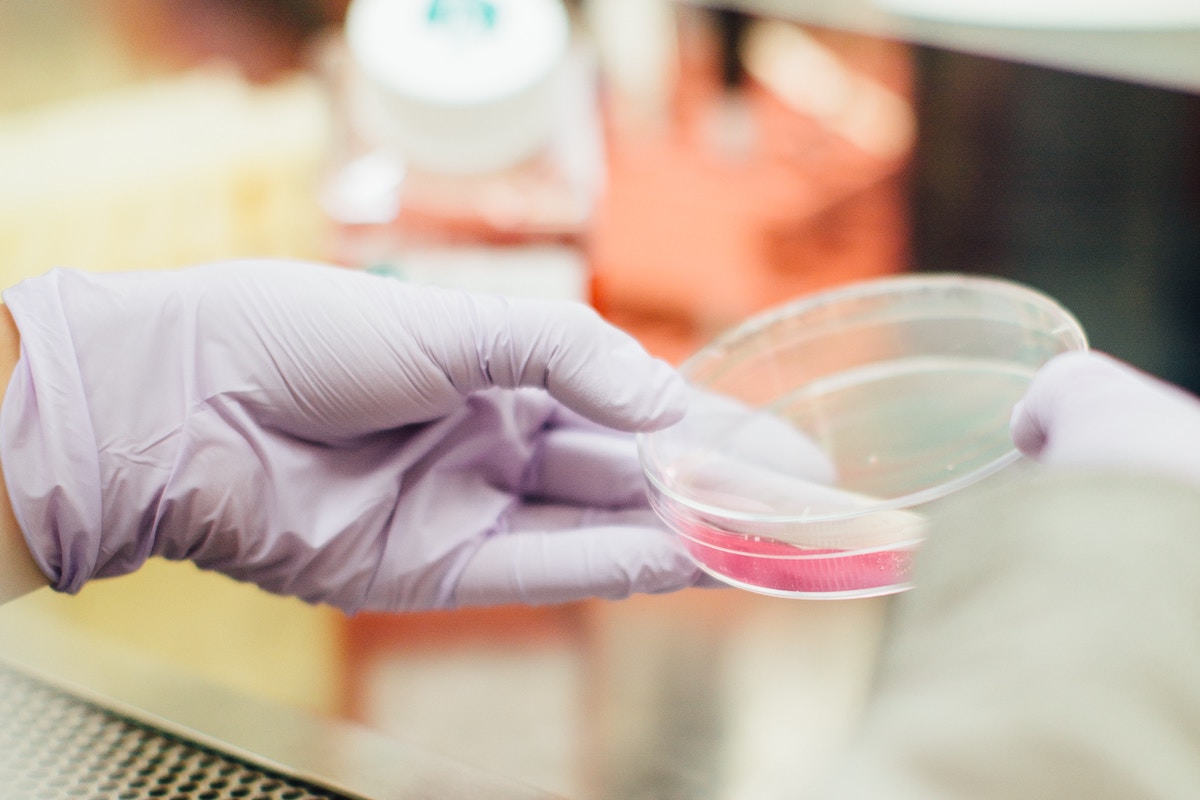

Recent advances in our understanding of the human gut microbiome have shown the complex community of microorganisms that live in our digestive tract are linked to all sorts of common health issues. However, putting this newfound knowledge to use is a lot more complicated than TV doctors and natural health bloggers would have you believe. Luckily, the folks at Viome have taken some pretty advanced science and made it simple with their Gut Intelligence Test and easy-to-use app.
Over the last 15 years, scientists have discovered that the complex community of symbiotic bacteria and other microorganisms that live in our digestive tract plays a huge role in our overall health. When your gut microbiome is out of balance, your body doesn’t absorb nutrients the way it should. This leads to inflammation, which affects almost every system in the body. Some studies have even linked gut health to specific diseases and conditions, including diabetes, obesity, irritable bowel syndrome, and colon cancer.
Of course, if you pay attention to current trends in the health and wellness industry, you have probably heard that certain foods and drinks that are supposed to be good for your gut. However, the reality is, improving gut health isn’t as simple as eating lots of yogurt and fermented vegetables. Every gut microbiome is completely unique, so the specific foods and drinks that are best for somebody else’s gut aren’t necessarily going to be best for you.
If you really want to optimize your diet to improve gut health, you have to start by taking a microbiome test.
That’s where Viome comes in.
A microbiome test is kind of like a DNA test, only instead of mapping out your genes, it maps out the organisms in your gut. What makes Viome’s test superior to others currently available is its proprietary microbe identification technology and advanced analytics engine.
Viome is the only company in the world with access to proprietary tech called “advanced metatranscriptomic sequencing technology,” which was originally developed at the Los Alamos National Laboratory for national security purposes. This technology helps them identify and quantify all the strains and species of microorganisms in your gut. Then, after they map everything out, they run this data through an advanced AI algorithm, which uses a massive database of information to come up with personalized nutrition recommendations.
Recent research has uncovered links between gut health and some of the health and wellness issues many of us struggle with every single day, such as weight management, sleep, and mental clarity, among other things. Viome’s gut intelligence test could provide the key to managing these issues.
Weight Loss
For years, people who struggle to lose weight have assumed weight issues were genetic. However, it turns out their problems might also be related to the gut microbiome. Today, scientists can analyze the composition of your gut microbiome and tell with 90-percent accuracy whether or not you are obese. They have also identified specific gut microbes that play a role in keeping obesity at bay. So if you have been struggling to lose weight, Viome’s Gut Intelligence Test could help you create a diet that feeds these obesity-busting microbes.
Sleep
There are a lot of factors that keep us from getting good sleep, including stress, anxiety, diet, and lack of exercise. For some people, however, gut imbalance could be the culprit. Researchers have discovered that there are several strains of bacteria in your gut that contribute to your body’s supply of melatonin, which is the hormone that regulates your sleep-wake cycle. Viome’s Gut Intelligence Test can help you nourish these strains to improve your body’s natural sleep regulatory system.
Mental Clarity
If you’ve ever been accused of thinking with your stomach, don’t worry. We all do. It turns out the microorganisms in our digestive tract play a major role in producing neurotransmitters, hormones, proteins, and other compounds necessary for sending signals to and from the brain. In other words, your gut can affect how you feel and think in a very tangible way. And Viome’s Gut Intelligence Test can help you figure out if there are any dietary changes that might actually improve your brain function.
When you order the Gut Intelligence Test, Viome sends you an easy to use at-home kit to collect your sample. After you return your sample by mail, Viome uses its advanced metatranscriptomic sequencing technology to determine what microorganisms live in your gut, how active they are, and what specific nutrients and toxins they produce from the food you eat. Viome’s powerful AI then creates customized dietary recommendations based on a massive and continually growing database of information.
These recommendations are designed to:
- increase microbial species associated with overall wellness
- minimize microbial species associated with poor health
- create the ideal ratio of proteins, carbohydrates, and fats for your diet
- encourage foods that are most compatible with your metabolism
- help you achieve and maintain a healthy weight
- increase your energy, focus, and well-being
In addition to these general dietary recommendations, you can also receive custom dietary recommendations based on specific health and wellness goals you select. And all results and recommendations are delivered via the Viome app on your mobile device, making them incredibly easy to put into action.
Viome’s Gut Intelligence Test is the most scientifically advanced microbiome test on the market, and right now kits are 62-percent off the regular price. So if you’re ready to take the guesswork out of gut health, order your kit today.
Futurism fans: To create this content, a non-editorial team worked with an affiliate partner. We may collect a small commission on items purchased through this page. This post does not necessarily reflect the views or the endorsement of the Futurism.com editorial staff.